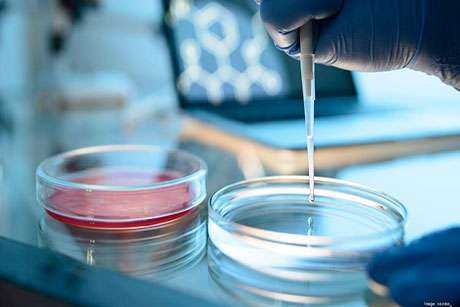

Принципы рандоминизированных клинических испытаний методов лечения онкологических заболеваний - рака
Добавил пользователь Алексей Ф. Обновлено: 10.01.2026
В настоящее время в клинической онкологии сложилась противоречивая ситуация, суть которой заключается в том, что хирурги и радиологи высказывают сомнения в существенной пользе адъювантной системной терапии при ранних стадиях рака молочной железы (РМЖ), в то время как химиотерапевты, базируясь на концепции B. Fisher о системном характере инвазивного РМЖ любого размера, полагают, что объем хирургического вмешательства и вообще интенсивность местного лечения не имеют существенного значения в конечном исходе заболевания, и лишь дополнительные системные лечебные воздействия в виде химиотерапии или гормонотерапии способны повлиять на естественный ход ("историю") заболевания, предотвратив у части больных фатальный его исход или, по крайней мере, отодвинуть на несколько месяцев или иногда лет его прогрессирование.
Такой диаметрально противоположный взгляд на биологическую сущность заболевания и, соответственно, лечебные подходы к нему вступает в противоречие с интересами больных РМЖ, судьба которых зависит от оптимального выбора лечения, адекватного конкретной клинической ситуации. Не случайно и в Европе и в Северной Америке периодически собираются комитеты экспертов (в Сан-Галлене [Швейцария], в Бетезде [США]) с целью выработки согласительных (consensus) рекомендаций по временным (на 2-3 года) стандартам лечения РМЖ. Однако и эти стандарты не лишены односторонности и не могут учесть всех индивидуальных черт заболевания. Сильной же стороной подобных стандартов является то, что они основаны, главным образом, на результатах крупных рандомизированных клинических испытаний, а именно они позволяют дать объективную оценку вклада локальной и системной терапии в излечение РМЖ.
Прежде всего, надо определиться, всегда ли инвазивный РМЖ является системным заболеванием. Если эти опухоли с самых начальных фаз инвазии являются системными, то всякая дискуссия о характере, объеме и интенсивности местного лечения теряет смысл. Признание системного характера РМЖ означает, что местное "хирургическое" воздействие, в сущности, должно низводиться к выполнению только биопсии первичного очага и сигнальных лимфатических узлов для получения информации об основных биологических характеристиках опухоли (гистологический тип, степень злокачественности, рецепторы стероидных гормонов, HER-2/neu статус, р53, состояние лимфатических узлов и т.д.), облегчающей индивидуальный выбор максимально эффективного системного лечения.
Хирургическое лечение оправдано, если существуют не только системные, но и локальные формы РМЖ. В этих случаях удаление опухоли до момента диссеминации означает излечение пациента. Прямых рандомизированных исследований по изучению вклада самогo хирургического лечения (по принципу "с операцией" против "без операции") естественно нет. Однако, согласно косвенным данным, легко определить, что отказ от хирургического лечения операбельных форм РМЖ почти всегда приводит к генерализации заболевания и гибели пациентов от отдаленных метастазов. Так по данным Mittra (2), касающимся заболеваемости и смертности от РМЖ в некоторых штатах Индии, в которых вообще не проводится хирургическое лечение, показатели заболеваемости практически равняются показателям смертности в соотношении 1:1. В то же время известно, что обычно эта пропорция выражается как 2:1 или 3:1, т.е. смертность от РМЖ в 2-3 раза уступает заболеваемости.
Если проанализировать результаты многочисленных клинических испытаний NSABP, проходивших на протяжении четверти века и возглавляемых B. Fisher (5, 6), автором гипотезы о скрытой ранней генерализации РМЖ, то легко заметить, что они в значительной мере опровергают взгляд о неизбежной системности РМЖ. Почти во всех проведенных в рамках NSABP испытаниях показатели 10- и 15-летней выживаемости в контрольных группах больных, подвергавшихся одному хирургическому лечению (без адъювантной химиотерапии или гормонотерапии), достигают 70-80%. Большая часть этих пациентов умирает в дальнейшем не от РМЖ, а от других наиболее распространенных причин. Кроме того, имеется полноценный многолетний материал Скандинавских канцер-регистров, охватывающих годы, когда вообще не проводилось системное адъювантное лечение РМЖ, в которых четко показана возможность излечения больных РМЖ после одного хирургического вмешательства. После 15-20 лет наблюдения большинство этих пациентов умирало не от РМЖ, а от других причин при отсутствии рецидива заболевания (2).
Именно поэтому хирургический метод, дополняемый в случае органосохраняющих операций лучевой терапией, остается основным лечебным воздействием, и от качества его проведения во многом зависит исход заболевания. Недавно проведенный в Оксфорде мета-анализ результатов лечения 20000 больных РМЖ с 20-летним периодом наблюдения убедительно показал (по крайней мере, для больных моложе 50 лет), что неадекватное местное лечение (без послеоперационной лучевой терапии) приводит не только к увеличению риска возникновения местно-регионарного рецидива на 60%, но и достоверному снижению выживаемости на 3-6% (3-9). И эта статистика касается больных РМЖ IIb-IIIa стадий (T2-3N1-2) с заведомо системным (по Fisher) заболеванием. Если же отдельно анализировать больных с клинически ранними стадиями РМЖ (I-IIa), подвергавшихся органосохраняющим операциям (свыше 4000 больных), то и здесь прослеживается аналогичная ситуация. Дополнительная интенсификация местного лечения с помощью послеоперационной лучевой терапии сокращает риск местного рецидива на 60% и улучшает 20-летнюю общую выживаемость на 3-6% (7, 9).
Отсюда следует, что неадекватное местно-регионарное лечение часто приводит к возникновению локально-регионарного рецидива заболевания (что, прежде всего, сказывается на качестве жизни пациента). Неадекватное локальное лечение фактически может переводить изначально локальное заболевание в системное со всеми вытекающими последствиями системного рецидива РМЖ.
Справедливости ради надо отметить, что сам B. Fisher, начиная с самых ранних экспериментальных работ 80-х годов и позже, уточняя свою гипотезу в условиях рандомизированных клинических испытаний, никогда не утверждал детерминированность системного характера инвазивного РМЖ. Диссеминация вообще свойственна инвазивным ракам любого органа. Применительно к РМЖ основной целью B. Fisher было опровержение механистической концепции W. Halsted о "центробежном" поэтапном распространении опухоли, которая была широко распространена в то время, а многими хирургами поддерживается и до сих пор. Fisher больше акцентировал внимание на угрозе раннего системного распространения РМЖ безотносительно размера опухоли (вплоть до микроинвазивных карцином). Согласно биологической концепции Fisher, между инвазивной опухолью молочной железы и организмом заболевшей может устанавливаться на какое-то время (иногда в течение нескольких лет) "равновесие", когда фактически системное заболевание длительно не прогрессирует до клинического проявления. Этим он, в сущности, объясняет возможность многолетней выживаемости больных РМЖ контрольных групп (не подвергавшихся адъювантному системному лечению) (6).
Не приходится сомневаться в том, что клинически ранние опухоли после, казалось бы, радикальных операций могут привести к гибели больных от отдаленных метастазов. Несомненно, существует потенциальная угроза скрытой диссеминации при любом инвазивном РМЖ. К счастью, она далеко не всегда реализуется. С точки зрения глубинных биологических свойств опухоли следовало бы учитывать и гетерогенность РМЖ, возможно даже, патогенетический полиморфизм, существование опухолей с полярно противоположными свойствами. Проведенное Моисеенко В.М. и М.Ф. Черномордиковой ретроспективное изучение ложноотрицательных маммограмм показало существование опухолей с периодом удвоения объема превышающим 900 дней, и опухолей с периодом удвоения менее 30 дней (1, 2). Первые могут существовать годами, не угрожая жизни больных, вторые же стремительно прогрессируют, рано метастазируют и протекают почти фатально. Существуют опухоли с наличием рецепторов к стероидным гормонам (ЭР+/ПР+) и относительно благоприятным клиническим течением, реагирующие на антиэстрогенную терапию, и рецептороотрицательные опухоли (ЭР-/ПР-), не чувствительные к эндокринотерапии, прогностически неблагоприятные. Последние, как правило, содержат рецепторы эпидермального фактора роста (EGFr), нередко характеризуются повышенной экспрессией гена HER-2/neu уже в фазе карциномы in situ, т.е. признаками, свидетельствующими об аутокринной регуляции опухолевого роста и абсолютной рефрактерности к любому виду эндокринотерапии. Патогенетический полиморфизм в значительной мере определяет отдаленные результаты как местного, так и системного лечения РМЖ. Однако до последнего времени не было достаточно надежных маркеров, определяющих особенности клинического течения ("естественной истории") заболевания. Информация о стероидных рецепторах, гене Р53, маркерах пролиферации (Ki67 и др.), EGF, HER-2/neu - важный шаг в поиске достоверных прогностических и предсказывающих биологических маркеров, облегчающих планирование адекватного лечения РМЖ.
Весь перечень данных многочисленных клинических испытаний свидетельствует о том, что РМЖ далеко не всегда является системным заболеванием. Маммографический скрининг значительно повышает удельный вес локальных (несистемных) форм РМЖ. Неадекватное локальное лечение не только увеличивает риск местно-регионарного рецидива, ухудшая качество жизни пациентов, но и может подтолкнуть остаточную опухоль к диссеминации, т.е. переходу от локальной к системной форме РМЖ.
Таким образом, идеология выбора лечения РМЖ построена на философском противоречии. Хирург, выполняя оперативное вмешательство различного объема, исходит из представления о локальном характере заболевания. Вместе с тем после завершения местного лечения (операция и/или лучевая терапия) невозможно исключить существования скрытых отдаленных метастазов (т.е. системности процесса). Даже у больных РМЖ с опухолями менее 1 см в диаметре при 10-летнем сроке наблюдения после окончания лечения в 10% случаев возможен рецидив заболевания. Неопределенность критериев отсутствия скрытых микрометастазов опухоли толкает к проведению системного адъювантного лечения (химио- или гормонотерапии) практически у всех больных операбельным РМЖ, хотя у 30% леченных она неэффективна, а у 60% не нужна вовсе.
Более существенные успехи получены при гормонотерапии РМЖ, возможно потому, что природа гормонозависимых и гормоночувствительных опухолей молочной железы более понятна уже со времен Beatson, выполнившего первые успешные операции по удалению яичников у больных РМЖ свыше 100 лет назад.
Семь проспективных рандомизированных исследований, оценивающих целесообразность послеоперационной лучевой терапии после органосохраняющего лечения, не смогли выделить какую-либо подгруппу больных, у которых можно было бы отказаться от лучевого лечения без угрозы рецидива заболевания (Vicini, 2002). В двух испытаниях, оценивающих замену лучевой терапии тамоксифеном, получены негативные результаты (9).
"Местное" лечение РМЖ (хирургическое и лучевое) продолжает развиваться и совершенствоваться в направлении органосохраняющего лечения. Проведение неоадъювантной химиотерапии или гормонотерапии расширяет возможности органосохраняющего лечения, однако при выполнении неадекватной резекции увеличивается угроза локальных рецидивов. Биопсия сигнальных (sentinel) лимфатических узлов постепенно вытесняет подмышечную диссекцию как стандартную процедуру стадирования РМЖ. Однако остается много вопросов в отношении отдаленных последствий столь ограниченной биопсии, способности хирургов освоить точность выполнения процедуры. Наибольшие дебаты вызывает вопрос, необходима ли полная подмышечная диссекция при наличии микрометастазов в сигнальном лимфоузле и как сказывается это на выживаемости (7). В исследовании Guys Hospital (7-9) неадекватная подмышечная диссекция приводила к ухудшению выживаемости.
В исследовании Quiet (9) было показано, что больные РМЖ с метастазами менее чем в 4 лимфоузлах, подвергавшиеся одному хирургическому лечению (без системной терапии), характеризовались высокой 20-летней выживаемостью (более 70%). Эти данные свидетельствуют о том, что далеко не у всех больных даже с наличием регионарных метастазов имеется "системное" (по Fisher) заболевание. В трех крупных рандомизированных исследованиях показано явное увеличение выживаемости у больных с метастазами в лимфатические узлы при условии проведения послеоперационной лучевой терапии (2, 7, 9).
Хотя исследование NSABP-B04, возглавлявшееся Fisher (4), часто цитируется как доказательство того, что подмышечная диссекция не имеет терапевтической ценности, по мнению M. Morrow (7), имеется много причин для пересмотра этого вопроса. В исследовании было всего 714 больных в трех группах (с аксиллярной диссекцией, с облучением подмышечной зоны и группа наблюдения), что недостаточно для обнаружения 5-10% отличия выживаемости в сравниваемых лечебных группах.
Нехирургические методы локального лечения, такие как лазер, высокочастотный ультразвук, криохирургия, направленные на разрушение первичной опухоли, интенсивно изучаются в качестве альтернативы хирургической эксцизии (2, 7, 9).
Во времена Холстеда идеи органосохраняющей хирургии были бы бессмысленны и даже опасны в силу того, что большинство выявляемых тогда опухолей превышали 8 см в диаметре, что соответствует современной Ш стадии. Не случайно частота локальных рецидивов достигала в те времена 80%, если выполнялись операции, меньшие по объему, чем радикальная мастэктомия по Холстеду. Решительный поворот в сторону органосохраняющего лечения произошел благодаря, прежде всего, внедрению маммографического скрининга, а не пересмотру концепции Холстеда в пользу системной гипотезы Фишера, согласно которой в первоначальной интерпретации объем локального лечения вообще не имеет значения в конечном исходе заболевания. Надо отметить, что до сих пор во многих странах, включая Россию, выполняются как операции Холстеда и Пейти, так и органосохраняющие операции, т.е. весь диапазон хирургических вмешательств, определяемый структурой выявляемых стадий рака. Приходится констатировать, что в странах Западной Европы и Северной Америки с многолетней практикой скрининга и высокой частотой ранних (I-IIa) стадий, достигающей 70-80%, удельный вес органосохраняющего лечения относительно невелик (около 40%). Наоборот, в странах и центрах, не опирающихся на маммографический скрининг, соответственно, с низкой частотой ранних стадий РМЖ (около 20%) удельный вес органосохраняющих операции неоправданно велик. Последние часто выполняются без учета отягчающих прогностических признаков: мультицентричности, наличия экстенсивного внутрипротокового компонента (ЕIC), высокой морфологической степени злокачественности.
Вклад различных (локальных и системных) методов лечения в достижение длительного (15-летнего) излечения хорошо прослеживается в результатах мета-анализа Оксфордского университета, касающегося 20 тыс. больных РМЖ (4). Если больные подвергались только местному лечению (операция + лучевая терапия), то через 15 лет выживало около 6 тыс. из 10 тыс. леченных, т.е. 60%. Если после операции больные получали адъювантное системное лечение (химиотерапия CMF, FAC + тамоксифен при ЭР+ опухолях), около 7 тыс. (т.е. 70%) переживали 15 лет после операции, остальные погибали в основном от отдаленных метастазов. Иными словами адъювантное системное лечение по стандартам 1985-1998 г. было эффективным приблизительно у 10% больных в долгосрочном плане. Конечно, нельзя утверждать, что все 60% больных, подвергшихся одному локальному лечению, погибли бы за эти годы без хирургического вмешательства. Имеются уникальные данные Bloom и Richardson (цит. по Моисеенко В.М., 1998) свидетельствующие о том, что половина не леченных больных РМЖ III-IV стадий выживают 2,7 года после установления диагноза. Исходя из этих наблюдений, можно предположить, что 15-20% больных операбельными формами РМЖ могли бы дожить до 15-летней отметки и без операции. Но даже и при таком допуске удельный вес выживших через 15 лет благодаря хирургическому вмешательству не ниже 40%, что явно выше вклада системного адъювантного лечения (около 10%).
Мало признать частый системный характер РМЖ и необходимость применения кроме локального лечения каких-то системных лечебных мероприятий. Необходимо располагать эффективными лекарственными средствами и схемами химио- или гормонотерапии, использование которых приводило бы к уничтожению скрытых микроочагов рака. Этого пока нет. Сегодня в долгосрочном плане (через 10-15 лет после операции) от стандартного системного лечения выигрывают лишь 10% больных. Кажется это не так много, однако при пересчете на 1 млн. ежегодно заболевающих РМЖ в мире, это означает 10 тыс. спасенных благодаря химио-гормонотерапии жизней.
Список литературы:
Участие в клинических исследованиях
Клинические исследования (КИ) — медицинские исследования на людях, необходимые для появления новых методов лечения. Это основной способ узнать, насколько лекарственный препарат или терапевтический метод безопасен и эффективен, а также возможность сравнить его с другими.
Все КИ оформляются в национальном регистре ICTRP и проводятся с соблюдением международных правил GCP. Соблюдение правил обеспечивает защиту прав участников и достоверность результатов испытаний.
На какие этапы и фазы делится изучение лекарственного средства?
До КИ проводят доклинический этап — в лабораториях, в пробирках и на животных. Если результаты этих исследований показывают, что препарат безопасен и эффективен, он допускается к клиническому этапу.
Клинические испытания процесс долгий и кропотливый, длящийся иногда десятилетиями.
1 фаза — Исследуемый препарат дают небольшому количеству добровольцев, 20-30 человек. Исследователи проверяют фармакокинетику препарата — что происходит с лекарством в организме, выявляют побочные эффекты, рассчитывают эффективную и безопасную дозу.
2 фаза — Исследование препарата на большой группе людей, 100-300 человек, чаще с конкретным диагнозом. Исследователи оценивают эффективность препарата в лечении заболевания и тяжесть побочных эффектов.
3 фаза — Сравнение действия препарата с плацебо или стандартными методами лечения на больших, в сотни и тысячи, группах людей. Исследователи изучают, имеет ли новый препарат преимущества перед уже существующими методами лечения.
Если новый лекарственный препарат успешно проходит все 3 фазы испытаний, его регистрируют для использования в разных странах.
После выхода лекарственного препарата на рынок продолжается контроль результатов его применения — постмаркетинговый мониторинг. Если при применении возникают серьезные нежелательные явления, врач сообщает об этом по установленной форме. Совет по клинической безопасности анализирует такие случаи и принимает меры. Все действия направлены на то, чтобы польза от применения препаратов превышала риски.
Какие бывают клинические исследования?
Открытые — участник и врач знают, какой препарат принимает пациент.
Простые слепые — участники не знают, какой препарат они принимают.
Двойные слепые — ни участник, ни врач не знают, какой препарат принимает пациент.
Рандомизированные — пациенты распределены в группы, получающие разное лечение, например, стандартное и новое, но сходные по многим параметрам: возрасту, полу, тяжести заболевания участников.
Плацебо-контролируемыми — одна группа пациентов получает исследуемый препарат, другая — плацебо, вещество без явных лечебных свойств.
Эталонный дизайн клинических исследований — рандомизированные контролируемые двойные слепые исследования, когда рандомизация (распределение в группы) осуществляется тайно, и контрольная группа получает плацебо, не отличимое от исследуемого препарата.
Что дает пациенту участие в клинических исследованиях?
Пациенты получают бесплатный доступ к новым методам лечения до их появления на рынке. Важно, что и обследования в рамках КИ всегда бесплатны.
Каковы риски?
Как стать участником КИ?
Вы можете спросить своего врача о проводимых в настоящее время КИ.
На сайте клинических исследований опубликованы данные обо всех, проходящих в настоящее время. На главной странице можно выбрать страну проведения и интересующее заболевание.
Что такое клинические исследования?
Клинические исследования (КИ) в онкологии - испытания для оценки эффективности и безопасности определенных видов лечения.
КИ проводят по строго соблюдаемому протоколу в соответствии с международным стандартом GCP. Если исследование одобрено, значит, оно безопасно для участников, обеспечивает их защиту и достоверность результатов. Неукоснительное следование правилам необходимо в первую очередь для безопасности пациента. Методология исследований в онкологии учитывает интересы пациента как высший приоритет.
КИ нужны, чтобы расширить знания о заболеваниях, в том числе, онкологических, оценить эффективность и безопасность новых методов диагностики и лечения. Исследуют лекарства, вакцины, другие биологические продукты, хирургические и радиологические манипуляции, новые аппараты для проведения обследования.
На какие этапы и фазы делятся КИ лекарственных средств?
Все препараты до регистрирации проходят несколько фаз исследований.
Доклиническая фаза - препарат исследуется в лаборатории, определяются его потенциальная эффективность и безопасность in vitro (в стекле, то есть “в пробирке”, вне организма человека).
При положительном результате начинается клинический этап, длящийся годами, иногда десятилетиями.
1-я фаза - препарат впервые вводится в организм человека. Основной предмет оценки - его безопасность. Изучаются фармакокинетика и фармакодинамика - распределение препарата в организме. Набор участников на этом этапе обычно небольшой - 20-30 добровольцев. Исследованиями занимается ограниченное количество лечебных учреждений. При успешном прохождении испытаний начинается следующая фаза.
2-я фаза - число участников исследований увеличивают. Цель этапа - оценка побочных действий и эффективности препарата.
3-я фаза - самая сложная и длительная. Ее цель - доказать, что предлагаемый новый метод (препарат, комбинация препаратов) эффективнее, чем стандартная терапия, рекомендуемая в подобных ситуациях. В испытаниях 3-й фазы могут применять плацебо («пустышку») для сравнения действия исследуемого препарата с ситуацией в отсутствии лечения.
Если исследуемый метод лечения успешно проходит все этапы, его регистрируют.
Но и после выхода на рынок препарат продолжают проверять - проводят постмаркетинговый мониторинг для подтверждения, что препарат действительно эффективен, и польза от его применения превышает риски.
Открытые - участник и врач знают, какой препарат принимает пациент.
Простые слепые - участники не знают, какой препарат они принимают.
Двойные слепые - ни участник, ни врач не знают, какой препарат принимает пациент.
Рандомизированные - пациенты распределены в группы, сходные по многим параметрам: возрасту, полу, тяжести заболевания участников, и получающие разное лечение, например, стандартное и новое.
Плацебо-контролируемыми - одна группа пациентов получает исследуемый препарат, другая - плацебо, вещество без лечебных свойств.
Эталонный дизайн клинических исследований - рандомизированные контролируемые двойные слепые исследования, когда рандомизация (распределение в группы) осуществляется тайно, и контрольная группа получает плацебо, не отличимое внешне от исследуемого препарата.
В чем смысл участия в исследованиях для пациента?
Клинические исследования спроектированы так, чтобы принести пациенту максимальную пользу.
Участие в испытаниях абсолютно бесплатно - все препараты, процедуры и анализы оплачиваются фармакологической компанией, проводящей исследование.
Пациенты получают лечение и обследование в строго соблюдаемые сроки, что немаловажно, учитывая проблемы с доступностью онкологической помощи.
Участники клинических исследований вносят вклад в развитие онкологической науки, помогая другим пациентам с аналогичным диагнозом в будущем получить эффективное лечение.
Пациенты, попавшие в группу стандартной терапии или плацебо, а не исследуемого препарата, тоже получают бонусы от участия в клиническом исследовании: постоянное наблюдение врача, возможность бесплатно и в срок проходить контрольные обследования. В некоторых исследованиях выполняют кроссовер, когда через определенное время группы экспериментального лечения и контроля меняются ролями.
В чем риски участия в клинических исследованиях?
Дополнительное неудобство: участие в КИ может требовать более частых визитов к врачу и строгого соблюдения расписания обследований.
Как присоединиться к клиническому исследованию?
К сожалению, в России не разработан удобный и актуальный русскоязычный поисковик доступных клинических исследований.
На главной странице можно выбрать страну, город и интересующее заболевание.
В разделе “Contact and locations” можно увидеть города и центры, в которых проводятся исследования, а также контакты, по которым с ними можно связаться.
Пациент может обсудить перспективу участия в КИ с лечащим врачом и попросить помощи в подборе исследования.
КИ занимаются только лечебные учреждения, способные обеспечить соблюдение норм GCP. В России наибольшее количество исследований проводится в крупных федеральных центрах.
Клинические исследования

Направление пациентов на бесплатные консультации, обследования и лечение в рамках клинических исследований по изучению инновационных лекарственных препаратов

Доступ к инновационным препаратам
Наблюдение в процессе лечения

Заведующая отделом клинических исследований, к.х.н. Полевая Юлия Петровна
- Ф.И.О. пациента
- диагноз
- номер протокола исследования
- выписку из истории болезни
Что надо знать о клинических исследованиях?
Что такое клинические исследования
В клинической практике стало нормой использовать новейшие противоопухолевые препараты, которые в результате лечения онкологических больных показывают очень эффективные результаты. В соответствии с общепринятыми правилами новые препараты до их официальной регистрации могут быть доступны для больных только в рамках клинических исследований. Именно поэтому клинические исследования являются неотъемлемой частью в разработке новейших инновационных лекарственных препаратов. Абсолютно все клинические исследования проходят с соблюдением специальных международных правил - GCP (Good Clinical Practice). Следование этим правилам служит гарантией того, что права пациентов, которые участвуют в исследованиях, защищены, а их результаты достоверны.
Фазы клинических исследований
Прежде чем препарат допускается к клиническим исследованиям, ему всегда предшествует процесс изучения в лабораториях в пробирках, или на лабораторных животных. Если в ходе доклинических исследований получены положительные результаты по безопасности и эффективности, препарат допускается на стадию клинических исследований.
Клинические исследования проходят в несколько фаз.
| На первоначальной фазе экспериментальный препарат тестируется с участием небольшой группы пациентов - 20-30 больных. Врачи оценивают его токсичность, определяют безопасную дозировку, идентифицируют побочные эффекты. |
| Во второй фазе расширяется контингент участников эксперимента от 100 до 300 пациентов. Проверяется его эффективность при конкретном заболевании и подробно оцениваются риски применения. |
| В третьей фазе в исследовании принимают участие от нескольких сотен, до нескольких тысяч пациентов (от одной до трех и более), чтобы на большой группе больных подтвердить эффективность препарата при определенном заболевании, выявить возникающие побочные эффекты и сравнить со стандартными способами лечения. |
| На четвёртой, заключительном этапе, который, как правило, проводится уже после регистрации препарата, получают дополнительную информацию о его безопасности, эффективности и оптимальном применении. Кроме того, пациенты получают возможность бесплатно проходить обследования и лечение, которые согласуются с принятыми международными стандартами. |


Проведение Исследований
В протоколе исследования описан подробный план проведения исследования. В нем указывается продолжительность исследования, критерии включения и исключения участников, расписание приема препаратов. В протоколе обязательно указывается перечень и расписание обследований и анализов, которые должен пройти и сдать пациент. Чтобы исследование могло начаться, протокол сначала должен пройти этическую экспертизу и получить одобрение Минздрава России, где «Совет по этике» осуществляют контроль за безопасностью пациентов, которые участвуют в исследовании на всём его протяжении. В ходе исследования с Комитетом по этике согласовываются все изменения в протоколе, а также в документах, которые предназначены для пациентов.
Рекомендации пациенту
Чтобы стать участником клинического исследования пациент должен ознакомиться со всеми аспектами этого процесса. В случае своего согласия пациент подписывает «Форму информированного согласия», после чего врач включает его в исследование. В течении всего исследования пациенты должны чётко следовать предписаниям протоколов: регулярно, в строго установленное время приходить в клинику для сдачи анализов, обследований и осмотров врачом. Это необходимо для более эффективной и безопасной оценки нового препарата. Врач в протоколе исследований устанавливает необходимый для лечения алгоритм посещений, что в обязательном порядке фиксируется в протоколе исследования. График визитов к врачу и все проводимые процедуры и обследования описываются в информированном согласии. Подписывая этот документ, пациент соглашается со всеми предложенными процедурами и графиком визитов.


Возможные риски и польза
Польза: качественно разработанные и проведенные клинические исследования для пациентов, соответствующих критериям для участия, позволяют получить доступ к инновационным препаратам и методам лечения, до того, как они станут широко доступными; получать высококвалифицированную медицинскую помощь в ведущих учреждениях здравоохранения в период проведения исследования; помочь другим, внося свой вклад в медицинские исследования.
Риски: существуют риски, связанные с клиническими исследованиями могут потребовать дополнительного времени и внимания по сравнению с обычным лечением, включая более частые визиты к врачу исследовательского центра, дополнительные приемы препаратов, пребывание в центре, ведение дневников приема препаратов или сложные схемы приема препаратов.
Также экспериментальное лечение может быть неэффективным для участника, могут возникать побочные эффекты экспериментального лечения. Перед участием в исследовании пациенту следует поговорить с врачом, оценить потенциальные риски и пользу, связанные с участием, однако, если всё удовлетворяете критериям отбора в исследование, окончательное решение об участии пациент должен принять самостоятельно.
Противоопухолевая лекарственная терапия, которая предлагается пациенту в рамках клинического исследования, всегда основана на международных стандартах по ведению пациентов с конкретным онкологическим заболеванием. Лечение проводится в отделениях клиники Московского научно-исследовательского онкологического института имени П.А. Герцена - филиале ФГБУ "НМИЦ радиологии" Минздрава России.
Принципы рандоминизированных клинических испытаний методов лечения онкологических заболеваний - рака
Артамонова Елена Владимировна
Заведующая отделением химиотерапии №1 ФГБУ «НМИЦ онкологии им. Н.Н. Блохина» Минздрава России, заведующая кафедрой онкологии и торакальной хирургии ФПК ГБУЗ «МОНИКИ им. М.Ф. Владимирского», профессор кафедры онкологии и лучевой терапии «РНИМУ им. Н.И. Пирогова», член правления RUSSCO, доктор медицинских наук, Москва
- Елена Владимировна, с чем, на Ваш взгляд, связан прорыв в лекарственном лечении немелкоклеточного рака легкого (НМРЛ) в последнее время?
- Прорыв в лечении рака легкого связан с успехами двух стратегических направлений развития онкологической науки. В первую очередь это, конечно, достижения онкоиммунологии, которые привели к открытию фундаментального механизма «ускользания» опухоли от иммунного ответа в результате активации пути PD1/PD-L1 с последующей разработкой препаратов, блокирующих «контрольные точки иммунитета» (анти-PD1 и анти-PD-L1 МКА). Второе важнейшее направление - углубление научных программ по молекулярно-генетическому тестированию НМРЛ и поиску онкогенных драйверных мутаций, ассоциированных с чувствительностью или резистентностью к таргетной терапии, например, открытие мутации Т790М, ассоциированной с резистентностью к ингибиторам тирозинкиназы EGFR 1 и 2 поколения.
- Является ли для Вас иммунотерапия революцией?
- Конечно, да, это настоящая революция в онкологии. Началом иммунотерапии злокачественных опухолей можно считать применение в 1890 г. токсина Colley на основе инфекционного возбудителя Erysipelothrix rhusiopathiae. Этот токсин индуцировал регрессию опухоли у некоторых пациентов, однако отсутствие теоретической базы в сочетании с непредсказуемостью результатов поставили крест на данном направлении. Прошло целых 100 лет непрерывных иммунологических исследований, важных теоретических открытий и, к сожалению, достаточно скромных практических результатов, пока в 1992 г. японский исследователь Ishida Yasumasa не открыл рецептор PD-1. После расшифровки роли этого рецептора в блокаде механизма распознавания и уничтожения опухолевой клетки иммунной системой в 2000 году Tasuku Honjo синтезировал МКА к PD-1. Наверное, именно это событие открыло новую эру иммунотерапии злокачественных опухолей, и в настоящее время анти-PD1 и анти-PD-L1 МКА используются при различных нозологиях и в различных клинических ситуациях/линиях терапии. Особенно впечатляющие результаты были достигнуты при распространенном НМРЛ с прогрессированием после предшествующей химиотерапии, а также в 1-й линии лечения у больных с высокой экспрессией PD-L1. Кроме того, получены первые данные о высокой эффективности иммуноонкологических препаратов в качестве консолидирующего лечения местно-распространенного нерезектабельного НМРЛ III стадии после завершения курса химиолучевой терапии (это первый успех консолидирующей стратегии за 20 лет исследований).
- Традиционно считается, что в нашей стране преобладает заболеваемость плоскоклеточным раком легкого. Эффективность иммунотерапии в этой группе такая же, как у пациентов с аденокарциномой?
- Данных по частоте различных гистологических типов НМРЛ в России очень немного. Существует анализ исследования EPICLIN Lung, в котором было показано, что более половины (54%) пациентов с НМРЛ - это плоскоклеточный вариант. Плоскоклеточный НМРЛ чаще развивается у курильщиков и характеризуется более агрессивным течением и худшим ответом на терапию по сравнению с аденокарциномой. В эпидемиологическом исследовании было показано, что двухлетняя общая выживаемость при аденокарциноме составляет 9,9%, а при плоскоклеточном раке - 7,2%. Кроме того, при плоскоклеточном варианте очень редко наблюдаются драйверные мутации (менее 10%), позволяющие назначить эффективную таргетную терапию. До появления иммунотерапии у этой группы пациентов не существовало эффективных опций лечения, особенно во второй линии.
Необходимо отметить, что в исследованиях по оценке эффективности иммунотерапии на смешанной когорте больных НМРЛ большую часть случаев составляли пациенты с неплоскоклеточным НМРЛ (то есть с аденокарциномой). Сравнение иммунотерапии и химиотерапии доцетакселом во второй линии лечения только плоскоклеточного НМРЛ было проведено в исследовании CheckMate 017. Показаны существенные преимущества иммунотерапии по сравнению с химиотерапией как по продолжительности жизни больных: однолетняя общая выживаемость составила 42% против 24%, двухлетняя - 23% против 8% соответственно, так и по частоте и длительности объективного ответа.
Очень важно, что экспрессия PD-L1 на опухолевых клетках не влияет на эффективность иммунотерапии при плоскоклеточном НМРЛ. Так, в исследовании CheckMate 017 (только плоскоклеточный НМРЛ) однолетняя общая выживаемость при экспрессии PD-L1 ≤1% и ≥1% составила 43% и 44% соответственно. Аналогичные цифры однолетней общей выживаемости были получены в подгруппах с более высоким уровнем экспрессии PD-L1 (≥5 - 45%, ≥10 - 47% соответственно). В отличие от плоскоклеточного гистологического подтипа, при неплоскоклеточном НМРЛ по данным подгрупповых анализов отмечена тенденция к увеличению показателей выживаемости на иммунотерапии с увеличением уровня экспрессии PD-L1.
Прямые сравнительные исследования эффективности иммунотерапии при различных гистологических подтипах НМРЛ не проводились (да и необходимости в этом нет). Если провести непрямое сравнение отдаленных результатов применения иммунотерапии во второй линии лечения НМРЛ, то можно отметить отсутствие серьезных различий в выживаемости: так, по данным исследований CheckMate 017 (плоскоклеточный подтип) и CheckMate 057 (неплоскоклеточный подтип), 2-летняя общая выживаемость составила 23% и 29% соответственно (эти результаты были доложены на ESMO 2016). Кроме того, по более ранним программам доложены уже 5-летние данные по общей выживаемости при проведении иммунотерапии в качестве 2-й линии лечения НМРЛ (исследование CA209-003): для плоскоклеточного НМРЛ 5-летняя общая выживаемость составила 16% (при историческом контроле 4%), для неплоскоклеточного НМРЛ - 15%.
- Таргетная терапия остается основой лечения данной категории пациентов, так как она увеличивает выживаемость, обеспечивает очень высокую частоту объективного ответа и характеризуется быстротой наступления регрессий, что очень важно при симптомном течении заболевания и большой распространенности опухолевого процесса. Что касается иммунотерапии, то по данным подгрупповых анализов и мета-анализа рандомизированных клинических исследований иммунотерапия не имеет преимуществ перед химиотерапией у больных с драйверными мутациями.
- Как таргетная терапия повлияла на 5-летнюю выживаемость?
- Доказано, что таргетная терапия улучшает клинические исходы у больных с онкогенными драйверными мутациями. Так, Kriset с соавторами проанализировали результаты лечения 938 пациентов с метастатической аденокарциномой легкого, разделив их на 3 группы: нет драйверной мутации, есть мутация, но проводилось традиционное лечение, есть мутация, проводилась соответствующая таргетная терапия. Медианы общей выживаемости в первых двух группах были одинаковыми (2,1 года и 2,4 года соответственно), в отличие от группы №3, где медиана общей выживаемости была значительно больше и составила 3,5 года.
По данным российской статистики можно отметить снижение одногодичной летальности больных НМРЛ с 54,3% в 2010 г. до 52,4% в 2012 г. и предположить, что определенный позитивный вклад в эту динамику был внесен в 2011 г. с изменением в нашей стране показаний для гефитиниба (первая линия терапии НМРЛ EGFRmut+).
- Пожалуйста, опишите Ваш алгоритм назначения лекарственного лечения пациенту с распространенным НМРЛ.
- Современная системная терапия распространенного НМРЛ включает в себя три направления: химиотерапию, таргетную терапию и иммунотерапию (ингибиторы контрольных точек иммунитета). Выбор оптимальной стратегии для каждого конкретного пациента осуществляется в результате персонализации и предусматривает: 1) выявление драйверных мутаций (и, соответственно, назначение таргетной терапии), 2) определение гистологического подтипа НМРЛ и выбор режима химиотерапии при отсутствии драйверных мутаций с последующим решением вопроса о проведении поддерживающей терапии, 3) определение экспрессии PD-L1 для назначения анти-PD1 моноклональных антител в первой линии или решение вопроса о более позднем применении иммуноонкологических препаратов с/без определения экспрессии PD-L1 (в зависимости от выбора конкретного моноклонального антитела.
Подробно алгоритм назначения лекарственного лечения пациенту с распространенным НМРЛ описан в рекомендациях RUSSCO.
- Можем ли мы с первого визита пациента запланировать сразу несколько линий терапии?
- Да, конечно, теперь у нас есть оптимальная последовательность назначения таргетных препаратов, химиотерапии (в зависимости от гистологии) и иммунотерапии, а наши возможности за последние 1-2 года значительно расширились.
Узнать больше о лечении рака легкого можно на
Международной междисциплинарной конференции «Немелкоклеточный рак легкого»
(1-2 марта 2018, Гостиница Интерконтиненталь Москва Тверская)
Читайте также:
